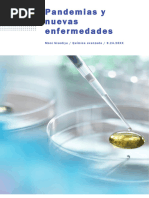

Actividad 2 Nombre Curso
Objetivo: Elaborar una infografía sobre una de las grandes pandemias de la historia
TXT p. 83
de la humanidad.
Reúnanse en grupos de 3 integrantes y realicen la siguiente investigación:
Presentación de la temática a investigar
A menudo pensamos que la biología es una La historia de la humanidad da cuenta de la
disciplina muy lejana, que se desarrolla en batalla que el ser humano ha librado contra
laboratorios y solo concierne a gente muy los microorganismos patógenos desde
especializada. Sin embargo, si revisamos tiempos muy antiguos, y la forma en que el
un poco la historia podríamos comprender conocimiento científico ha logrado eliminar
la enorme transcendencia que esta ciencia y reducir la propagación de estos pequeños
tiene y ha tenido en la vida del ser humano. invasores tan peligrosos. En este trabajo la
Un ejemplo claro de esto lo constituye el invitación es a descubrir cuáles han sido los
conocimiento en torno a los microorganismos, microorganismos que se han expandido en el
muchos de ellos benéficos, pero otros con un planeta hasta alcanzar el nivel de pandemia,
poder inimaginable de destruir la vida humana hacer un análisis de las condiciones sociales
en poco tiempo. De hecho, algunos de ellos han y culturales en que se propagó cada uno y a
producido un número de víctimas mucho mayor conocer las consecuencias históricas de su
que las guerras mundiales. irrupción en la vida del ser humano.
Recursos digitales
1 ¿Cómo las medidas de higiene que existían en el
Para comenzar, ingresen el código BN7BU3P002A
pasado propiciaron la aparición de epidemias
al siguiente sitio web [Link], donde
y pandemias? encontrarás un video que relata las grandes
pandemias que ha enfrentado la humanidad desde
la invención de la escritura. Luego, respondan
las preguntas.
2 ¿Cómo el aumento de la población mundial influyó en la aparición de epidemias y pandemias?
3 ¿De qué manera las epidemias y pandemias afectan la situación política y demográfica del mundo?
1
�4 ¿Qué medidas preventivas se adoptaron para combatir las primeras epidemias y pandemias?
¿Cuál será nuestro desafío?
Cada grupo debe seleccionar una enfermedad que se haya convertido en pandemia. Deberán
investigar sobre esta enfermedad, identificando y relacionando aspectos biológicos e históricos
de cada una. Después de realizar una búsqueda de información en diferentes fuentes
bibliográficas, deberán elaborar una infografía, que sea atractiva desde el punto de vista
comunicacional y que muestre la información de manera creativa y sencilla. Para ello, se asignará
al azar una de las siguientes pandemias:
• Gripe española • Pandemia del Sida • Séptima pandemia del
cólera
• Peste negra • Plaga de Justiniano
• COVID-19
5 ¿Qué información necesitan para cumplir con este desafío?
6 ¿Qué es una infografía y cuáles son sus características?
¿Cómo ejecutamos este desafío?
Para abordar este desafío, es necesario que trabajemos de manera interdisciplinaria:
Historia, Geografía
Ciencias Naturales Artes Visuales y Tecnología
y Ciencias sociales
Características de las
epidemias y pandemias, Contexto histórico, social
Elaboración de una
considerando el patógeno y demográfico en que se
infografía.
que la produce, sus desarrolló la pandemia.
síntomas, entre otros.
2
�Para orientar su investigación, respondan las siguientes preguntas. Si lo requieren, soliciten
apoyo a sus docentes de las respectivas asignaturas:
• ¿Qué es una epidemia? ¿Cuál es la diferencia entre una pandemia y una epidemia?
• ¿Qué tipo de microorganismo produce la enfermedad que investigan?
Ciencias • ¿Qué síntomas produce?
Naturales
• ¿Cómo se contagia? ¿Qué medidas de higiene hubiesen prevenido su propagación?
• ¿En qué época ocurrió la pandemia?
• ¿Cómo vivían las personas en la época en que se desarrolló la pandemia?
Historia,
Geografía
y Ciencias • ¿En qué lugares del mundo se propagó la pandemia?
sociales
• ¿Existía algún tipo de práctica médica en la época en que se desarrolló la pandemia?
¿Cómo apoyaba la medicina a sus pacientes?
• ¿Qué elementos visuales incluye una infografía?
Artes
Visuales y
Tecnología • ¿Qué herramienta puedo utilizar para fabricarla?
3
�Planificación y diseño de la infografía
Antes de comenzar a escribir, realicen un proceso de ideación. Anoten sus ideas y lleguen a acuerdos.
Para realizar la ideación de su infografía, pueden guiarse por las siguientes preguntas:
7 ¿Qué ideas debemos transmitir respecto de la pandemia que investigamos?
8 ¿Qué imágenes o ilustraciones podrían acompañar estas ideas?
9 ¿Cómo deberíamos organizar estas ideas en la infografía para que sean coherentes?
Elaboración de la infografía
Ahora ¡manos a la obra! Distribúyanse el trabajo, de manera que haya quienes se encarguen
de elaborar los textos y quienes elaboren las gráficas. Revisen el material varias veces hasta
que consideren que quedó como ustedes quieren.
Evaluación
Como equipo de trabajo, reflexionen en torno a
Trabajar en equipo de manera
las siguientes preguntas:
responsable, construyendo
• ¿Qué dificultades y beneficios creen que tuvo el trabajo relaciones de cooperación basadas
en equipo? en la confianza mutua y resolviendo
• ¿De qué manera aprovecharon los talentos e intereses adecuadamente los conflictos.
de cada integrante?
• ¿Qué hicieron para llegar a acuerdos y consensos? ¿Por qué Utilizar aplicaciones para presentar,
es necesario en el trabajo en equipo llegar a acuerdos? representar, analizar y modelar
información y situaciones,
• ¿En qué medida la tecnología les permitió enfrentar el desafío comunicar ideas y argumentos,
de construir su infografía? comprender y resolver problemas
• ¿De qué manera la tecnología contribuye a mejorar la de manera eficiente y efectiva,
comunicación de ideas entre las personas? aprovechando múltiples medios
(texto, imagen, audio y video).